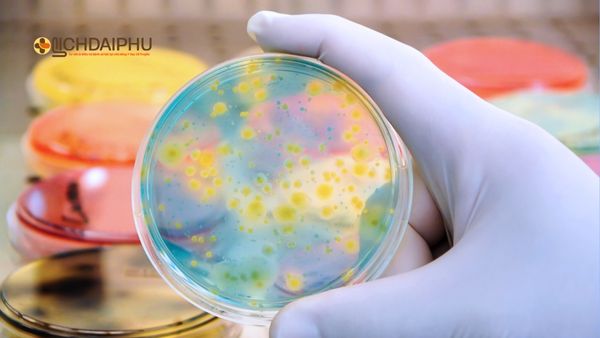
Các phương pháp xét nghiệm bệnh lậu phổ biến hiện nay – Hình ảnh minh họa quy trình nuôi cấy và phân tích vi khuẩn lậu trong phòng xét nghiệm hiện đại. Bác sĩ cầm đĩa petri chứa mẫu nuôi cấy vi khuẩn trong phòng xét nghiệm, minh họa các phương pháp xét nghiệm bệnh lậu phổ biến hiện nay như PCR, soi tươi và nuôi cấy.

(Lịch Đại Phu) – Bệnh lậu là một trong những bệnh xã hội nguy hiểm, có tốc độ lây lan nhanh và gây ra nhiều biến chứng nếu không được phát hiện sớm. Tuy nhiên, nhiều người vẫn băn khoăn xét nghiệm bệnh lậu ở đâu chính xác tại Hà Nội để đảm bảo kết quả đúng và có hướng điều trị phù hợp.
- Dấu hiệu nhận biết bệnh lậu sớm cho người sống tại Hà Nội
- Bệnh lậu ở Hà Nội đang trẻ hóa – Vì sao giới trẻ dễ mắc?
- Top 10 địa chỉ khám chữa bệnh lậu uy tín ở Hà Nội

Bài viết này sẽ giúp bạn hiểu rõ quy trình xét nghiệm bệnh lậu, địa chỉ xét nghiệm uy tín tại Hà Nội, chi phí và những lưu ý quan trọng khi đi kiểm tra.
I. Tại sao cần xét nghiệm bệnh lậu sớm?
Bệnh lậu do vi khuẩn Neisseria gonorrhoeae gây ra, chủ yếu lây truyền qua đường tình dục không an toàn. Ngoài ra, bệnh còn có thể lây qua tiếp xúc với dịch mủ chứa vi khuẩn hoặc từ mẹ sang con khi sinh thường.
Điều đáng lo ngại là nhiều người bị nhiễm lậu không có triệu chứng rõ ràng, khiến việc phát hiện sớm trở nên khó khăn. Nếu để lâu, vi khuẩn lậu có thể gây ra nhiều biến chứng nghiêm trọng như:
-
Ở nam giới: viêm mào tinh hoàn, viêm tuyến tiền liệt, giảm khả năng sinh sản.
-
Ở nữ giới: viêm cổ tử cung, viêm vùng chậu, vô sinh, thai ngoài tử cung.
-
Ở trẻ sơ sinh: có thể bị viêm kết mạc, mù lòa bẩm sinh.
Vì vậy, xét nghiệm sớm bệnh lậu là cách duy nhất để phát hiện chính xác và điều trị kịp thời, tránh hậu quả đáng tiếc.
II. Khi nào nên đi xét nghiệm bệnh lậu?
Bạn nên chủ động đi xét nghiệm bệnh lậu nếu có một trong những dấu hiệu hoặc yếu tố sau:
1. Dấu hiệu nghi ngờ mắc bệnh lậu
-
Tiểu buốt, tiểu rát, tiểu ra mủ.
-
Dịch tiết bất thường ở dương vật hoặc âm đạo (màu vàng, xanh, có mùi hôi).
-
Đau khi quan hệ, chảy máu sau quan hệ.
-
Ngứa rát vùng kín, sưng tấy lỗ niệu đạo.
-
Ở nữ: khí hư ra nhiều, đau bụng dưới.
-
Ở nam: đầu dương vật sưng đỏ, có mủ đặc vào buổi sáng.

2. Có hành vi nguy cơ cao
-
Quan hệ tình dục không dùng bao cao su.
-
Quan hệ với nhiều người hoặc với người nghi mắc bệnh xã hội.
-
Đã từng mắc các bệnh lây qua đường tình dục khác (như giang mai, sùi mào gà, HIV…).
-
Phụ nữ mang thai có tiền sử lây nhiễm lậu hoặc bạn tình mắc bệnh.
Nếu có một trong các yếu tố trên, bạn nên đi xét nghiệm ngay, kể cả khi chưa thấy triệu chứng rõ ràng.
III. Các phương pháp xét nghiệm bệnh lậu phổ biến hiện nay
Tùy vào giai đoạn và biểu hiện bệnh, bác sĩ sẽ chỉ định một hoặc nhiều phương pháp xét nghiệm khác nhau. Dưới đây là 4 phương pháp xét nghiệm lậu chính xác nhất hiện nay:
1. Xét nghiệm dịch niệu đạo hoặc dịch âm đạo
Bác sĩ sẽ lấy mẫu dịch ở niệu đạo (đối với nam) hoặc âm đạo (đối với nữ) để soi tươi hoặc nhuộm Gram. Nếu phát hiện vi khuẩn Neisseria gonorrhoeae hình hạt cà phê, kết quả sẽ dương tính.
- Ưu điểm: nhanh, có kết quả trong 30 phút.
- Nhược điểm: độ chính xác khoảng 80–90%, phụ thuộc vào kỹ thuật viên và giai đoạn bệnh.
2. Xét nghiệm PCR (sinh học phân tử)
Phương pháp PCR giúp phát hiện ADN của vi khuẩn lậu trong mẫu nước tiểu, dịch niệu đạo hoặc dịch âm đạo.
- Ưu điểm: độ chính xác gần như tuyệt đối (trên 99%), phát hiện được bệnh ngay cả khi không có triệu chứng.
- Nhược điểm: chi phí cao hơn, cần phòng xét nghiệm đạt chuẩn.
3. Xét nghiệm nuôi cấy vi khuẩn
Lấy mẫu bệnh phẩm và nuôi cấy trong môi trường đặc biệt để xem vi khuẩn có phát triển không.
- Ưu điểm: cho kết quả khẳng định chắc chắn, có thể kiểm tra lậu kháng thuốc.
- Nhược điểm: thời gian lâu hơn (1–3 ngày), đòi hỏi thiết bị chuyên dụng.
4. Xét nghiệm máu
Dùng để phát hiện kháng thể hoặc dấu hiệu nhiễm khuẩn do lậu cầu gây ra. Phù hợp khi bệnh đã chuyển sang giai đoạn mãn tính.
- Ưu điểm: dễ thực hiện, hỗ trợ chẩn đoán giai đoạn muộn.
- Nhược điểm: không phát hiện được bệnh lậu giai đoạn đầu.
Xem thêm: Cách đọc kết quả xét nghiệm bệnh lậu: Các chỉ số, dấu hiệu dương tính
IV. Xét nghiệm bệnh lậu ở đâu chính xác tại Hà Nội?
Hiện nay tại Hà Nội có nhiều cơ sở y tế, phòng khám và bệnh viện có thể thực hiện xét nghiệm bệnh lậu. Tuy nhiên, để đảm bảo độ chính xác và bảo mật thông tin, bạn nên lựa chọn những địa chỉ uy tín, có chuyên khoa bệnh xã hội.
Dưới đây là 5 địa chỉ xét nghiệm bệnh lậu chính xác và đáng tin cậy nhất tại Hà Nội:
1. Bệnh viện Da liễu Trung ương
-
Địa chỉ: 15A Phương Mai, Đống Đa, Hà Nội
-
Đặc điểm: Bệnh viện Da liễu Trung ương là tuyến đầu cả nước về chuyên khoa Da liễu – Bệnh lây truyền qua đường tình dục (STD). Đây là nơi chẩn đoán, xét nghiệm và điều trị các bệnh xã hội như: lậu, giang mai, sùi mào gà, HIV, chlamydia… với độ chính xác và uy tín cao nhất miền Bắc. Phòng xét nghiệm đạt chuẩn ISO, trang bị hệ thống máy PCR sinh học phân tử hiện đại, giúp phát hiện vi khuẩn lậu ngay cả khi ở giai đoạn tiềm ẩn.
Thực hiện đầy đủ các phương pháp xét nghiệm lậu:
-
-
Soi tươi, nhuộm Gram
-
Nuôi cấy vi khuẩn Neisseria gonorrhoeae
-
Xét nghiệm PCR định danh vi khuẩn
-
Xét nghiệm máu phát hiện kháng thể
-
Có khả năng xét nghiệm đồng thời nhiều bệnh xã hội, tiết kiệm thời gian cho người bệnh.
Có đầy đủ phương pháp xét nghiệm lậu: nhuộm Gram, PCR, nuôi cấy.
- Hạn chế: thường xuyên quá tải, phải xếp hàng lấy số sớm.
2. Bệnh viện Bạch Mai – Khoa Da liễu
-
Địa chỉ: 78 Giải Phóng, Đống Đa, Hà Nội
-
Đặc điểm: Khoa Da liễu – Bệnh viện Bạch Mai là một trong những đơn vị uy tín hàng đầu tại Hà Nội trong chẩn đoán và điều trị các bệnh lây truyền qua đường tình dục, đặc biệt là bệnh lậu. Khoa được trang bị hệ thống máy xét nghiệm PCR hiện đại, cho kết quả nhanh và chính xác cao. Đội ngũ bác sĩ chuyên khoa nhiều kinh nghiệm, từng điều trị hàng nghìn ca bệnh phức tạp. Quy trình khám – xét nghiệm – tư vấn được thực hiện khép kín, bảo mật tuyệt đối thông tin người bệnh. Đây là lựa chọn phù hợp cho những ai muốn xét nghiệm bệnh lậu tại cơ sở bệnh viện lớn, uy tín và an toàn.
-
Hạn chế: chi phí cao, quy trình nhiều bước, đông bệnh nhân.
3. Bệnh viện Đại học Y Hà Nội
-
Địa chỉ: 1 Tôn Thất Tùng, Đống Đa, Hà Nội
-
Đặc điểm: Bệnh viện Đại học Y Hà Nội là cơ sở y tế tuyến trung ương nổi tiếng với đội ngũ giáo sư, tiến sĩ, bác sĩ đầu ngành trực tiếp thăm khám.
Khoa Da liễu – Bệnh xã hội của bệnh viện chuyên xét nghiệm và điều trị các bệnh lây truyền qua đường tình dục, trong đó có bệnh lậu, bằng phương pháp PCR hiện đại cho kết quả nhanh và chính xác gần như tuyệt đối. Cơ sở vật chất khang trang, quy trình khám khép kín, đảm bảo riêng tư và bảo mật thông tin bệnh nhân. Người bệnh có thể đặt lịch trước để được khám nhanh, không phải chờ đợi lâu.
-
Hạn chế: cần đặt lịch trước, không nhận khám ngoài giờ.
4. Viện Nam Học & Hiếm Muộn Hà Nội
Địa chỉ: 431, Tam Trinh, Hoàng Mai, Hà Nội
Đặc điểm nổi bật:
Chuyên khoa Nam học – Tiết niệu – Bệnh xã hội:
-
- Viện có đội ngũ bác sĩ chuyên sâu về Nam học, phụ trách chẩn đoán và điều trị các bệnh lây truyền qua đường tình dục, trong đó có bệnh lậu, chlamydia, giang mai, HPV, HIV…
Trang thiết bị xét nghiệm hiện đại:
-
-
Ứng dụng công nghệ PCR để phát hiện chính xác vi khuẩn Neisseria gonorrhoeae ngay cả ở giai đoạn sớm.
-
Có hệ thống nuôi cấy vi khuẩn và xét nghiệm kháng thuốc, giúp bác sĩ chọn đúng phác đồ điều trị.
-
Độ chính xác cao, bảo mật thông tin tuyệt đối:
-
-
Kết quả xét nghiệm được xử lý trong phòng lab chuẩn quốc tế.
-
Thông tin người bệnh được bảo mật, đảm bảo sự riêng tư tuyệt đối.
-
Đội ngũ bác sĩ giàu kinh nghiệm:
-
-
Nhiều bác sĩ từng công tác tại Bệnh viện Việt Đức, Bạch Mai, và Đại học Y Hà Nội.
-
Có chuyên môn sâu trong điều trị bệnh lậu kháng thuốc, bệnh lậu tái phát, bệnh lậu mãn tính.
-
Dịch vụ khám nhanh, hỗ trợ tư vấn kín đáo:
-
-
Có thể đặt lịch trước để không phải chờ đợi.
-
Tư vấn riêng tư dành cho các bệnh nhân e ngại hoặc có yếu tố nhạy cảm.
-
Ưu điểm khi xét nghiệm bệnh lậu tại Viện Nam học và Hiếm muộn Hà Nội:
-
Kết quả chính xác > 99% bằng phương pháp PCR.
-
Có thể xét nghiệm đồng thời nhiều bệnh xã hội khác.
-
Phí xét nghiệm hợp lý, công khai minh bạch theo quy định của Bộ Y tế.
Giờ làm việc: 7h30 – 17h00 (thứ 2 đến thứ 7), nghỉ chủ nhật
Liên hệ đặt lịch:
-
Hotline: 024.3634.3636
-
Website: afhanoi.com
-
Tư vấn miễn phí: qua tổng đài hoặc trực tiếp tại quầy lễ tân Bệnh Viện.
5. Bệnh viện Trung ương Quân đội 108
Bệnh viện Trung ương Quân đội 108 là cơ sở y tế tuyến cuối của Quân đội, tọa lạc tại số 1 Trần Hưng Đạo, quận Hai Bà Trưng, Hà Nội.
Thời gian làm việc: từ 7h00 – 17h30 (thứ 2 đến thứ 7).
Bệnh viện có hệ thống xét nghiệm hiện đại đạt chuẩn quốc tế, áp dụng công nghệ PCR và nuôi cấy vi khuẩn lậu cho kết quả nhanh, chính xác cao. Đội ngũ bác sĩ chuyên khoa giỏi, giàu kinh nghiệm, đảm bảo quy trình khám – lấy mẫu – trả kết quả khép kín, bảo mật tuyệt đối thông tin người bệnh. Đây là địa chỉ đáng tin cậy cho những ai cần xét nghiệm bệnh lậu an toàn, chính xác và chuyên nghiệp tại Hà Nội.
V. Chi phí xét nghiệm bệnh lậu tại Hà Nội
Chi phí xét nghiệm bệnh lậu tùy thuộc vào phương pháp thực hiện và cơ sở y tế. Dưới đây là bảng giá tham khảo:
| Phương pháp xét nghiệm | Chi phí (VNĐ) | Thời gian có kết quả |
|---|---|---|
| Soi tươi, nhuộm Gram | 100.000 – 200.000 | 30 phút – 1 giờ |
| PCR (ADN vi khuẩn lậu) | 500.000 – 900.000 | 1 – 3 giờ |
| Nuôi cấy vi khuẩn | 300.000 – 700.000 | 1 – 3 ngày |
| Xét nghiệm máu | 150.000 – 300.000 | Trong ngày |
Lưu ý: Mức giá có thể thay đổi tùy thời điểm và dịch vụ kèm theo. Một số phòng khám tư nhân có thể thu phí tư vấn hoặc lấy mẫu riêng.
VI. Quy trình xét nghiệm bệnh lậu tại Hà Nội
Quy trình xét nghiệm thường bao gồm 4 bước cơ bản sau:
-
Đăng ký khám và tư vấn ban đầu
Bác sĩ sẽ hỏi về triệu chứng, thời gian nghi ngờ mắc bệnh, tiền sử quan hệ. -
Lấy mẫu bệnh phẩm
Tùy vào giới tính, bác sĩ sẽ lấy mẫu dịch niệu đạo, âm đạo hoặc nước tiểu. -
Thực hiện xét nghiệm
Mẫu bệnh phẩm được đưa vào phòng xét nghiệm để soi, nuôi cấy hoặc tách ADN. -
Nhận kết quả và tư vấn điều trị
Nếu dương tính, bác sĩ sẽ hướng dẫn điều trị bằng kháng sinh hoặc thuốc Đông y tùy tình trạng.

VII. Lưu ý trước khi đi xét nghiệm bệnh lậu
Để kết quả xét nghiệm đạt độ chính xác cao, bạn nên:
-
Không đi tiểu ít nhất 2 giờ trước khi lấy mẫu.
-
Không sử dụng thuốc kháng sinh 3–5 ngày trước xét nghiệm.
-
Tránh quan hệ tình dục trong vòng 24 giờ trước khi xét nghiệm.
-
Thông báo rõ với bác sĩ nếu bạn đang dùng thuốc điều trị bệnh khác.
VIII. Xét nghiệm lậu âm tính có chắc chắn không mắc bệnh?
Không phải lúc nào kết quả âm tính cũng đồng nghĩa với không mắc bệnh.
Nếu bạn xét nghiệm quá sớm (trong vòng 2–5 ngày sau khi tiếp xúc nguy cơ), vi khuẩn chưa kịp phát triển đủ để phát hiện.
Trong trường hợp nghi ngờ, nên xét nghiệm lại sau 7–10 ngày để khẳng định chắc chắn.
IX. Kết hợp xét nghiệm và điều trị an toàn
Sau khi có kết quả dương tính, bạn nên:
-
Điều trị theo phác đồ bác sĩ chỉ định, đủ liều – đủ ngày.
-
Không quan hệ tình dục trong thời gian điều trị.
-
Khám và điều trị cho cả bạn tình để tránh tái nhiễm chéo.
-
Kết hợp thuốc Đông y hỗ trợ đào thải vi khuẩn, tăng miễn dịch niệu đạo, giảm tái phát.
Phương pháp Đông – Tây y kết hợp hiện được nhiều người lựa chọn vì hiệu quả lâu dài, không kháng thuốc, không tái phát.
X. Kết luận: Nên xét nghiệm bệnh lậu ở đâu tại Hà Nội?
Nếu bạn đang băn khoăn xét nghiệm bệnh lậu ở đâu chính xác tại Hà Nội, hãy ưu tiên những địa chỉ:
- Có bác sĩ chuyên khoa bệnh xã hội.
- Sử dụng phương pháp PCR hoặc nuôi cấy hiện đại.
- Cam kết bảo mật thông tin bệnh nhân.
- Có dịch vụ tư vấn và điều trị toàn diện, đặc biệt là hỗ trợ điều trị Đông y an toàn.

Trong đó, Đông y Lịch Đại Phu là một lựa chọn đáng tin cậy điều trị bệnh lậu hiệu quả bằng Đông y, phù hợp với những ai muốn chữa triệt để mà không lo tái phát.
🔸 Thông tin liên hệ: Đông y Lịch Đại Phu
📍 Địa chỉ: Khương Đình – Thanh Xuân – Hà Nội
📞 Hotline/Zalo tư vấn: [Liên hệ ngay để được hướng dẫn xét nghiệm & điều trị kín đáo]
🌿 Giờ làm việc: 8h00 – 20h00 (kể cả cuối tuần và ngày lễ)





